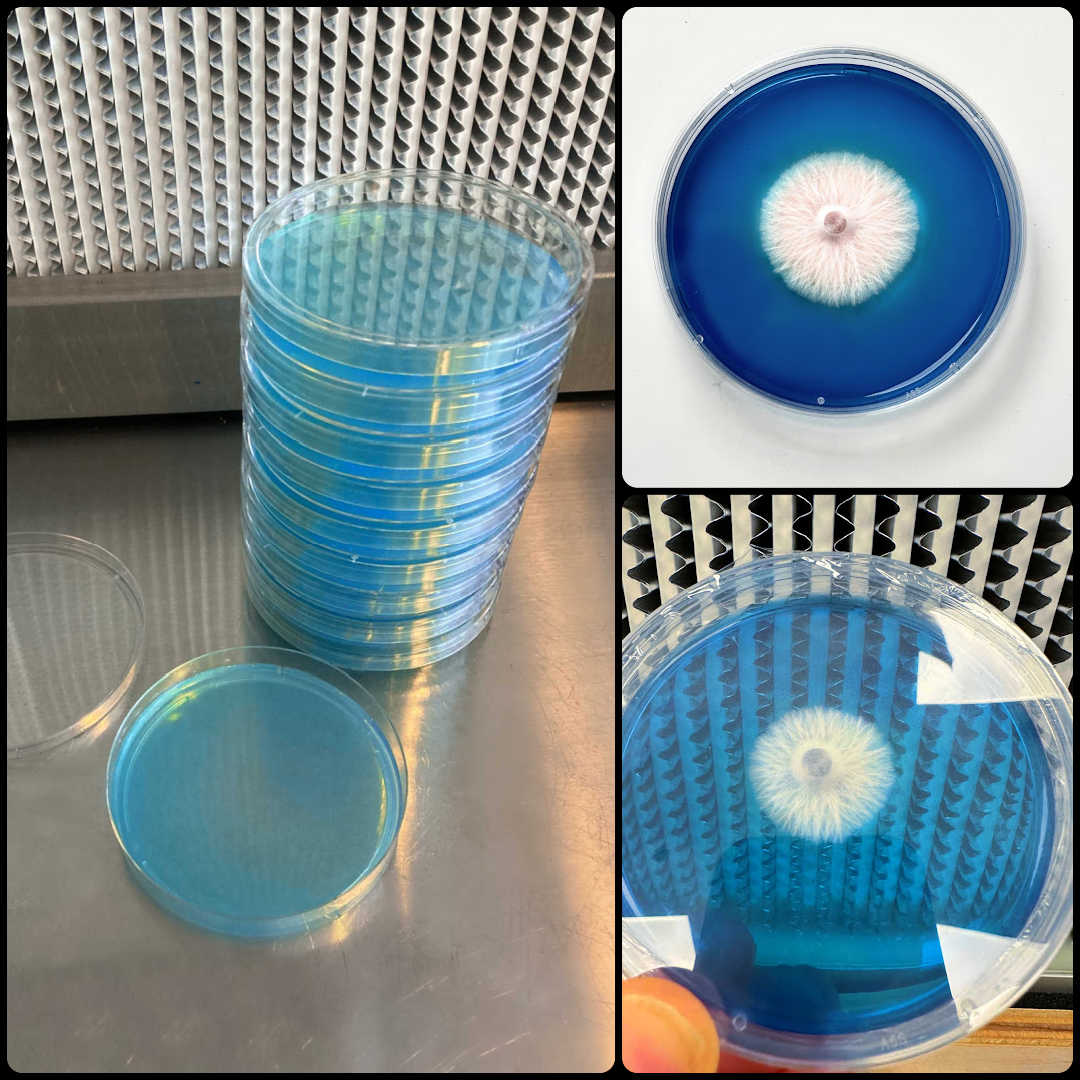

Rapid Rhizo Pre-Poured Sterilized Agar Plates (10-Pack)
Rapid Rhizo Pre-Poured Sterilized Agar Plates (10-Pack) is backordered and will ship as soon as it is back in stock.
Couldn't load pickup availability
Description
Description
Rapid Rhizo Pre-Poured Sterilized Agar Plates (10-Pack)
Now in a 10-Pack · Freshly Poured Daily · Made for Aggressive Mycelium Growth
Level up your mycology work with our Rapid Rhizo Agar Plates, now available in a convenient 10-pack. Designed for serious researchers, these pre-poured plates are formulated with a custom nutrient and yeast blend that encourages fast, aggressive rhizomorphic growth, making it easier to isolate your strongest genetics.
Unlike other pre-poured agar that sits on shelves for weeks, our plates are made fresh daily and sealed in polyolefin packaging for long-lasting potency and maximum freshness. Whether you're cleaning cultures, transferring isolates, or showcasing final transfers, Rapid Rhizo provides the aggressive edge experienced cultivators seek.
Key Features:
- 10 Rapid Rhizo Agar Plates – 90mm polystyrene Petri dishes
- Promotes Rhizomorphic Growth – ideal for strain isolation and genetic refinement
- Pressure Sterilized & Poured in a laminar flow hood for contaminant-free purity
- Chloramphenicol added to help resist contamination
- Store in the fridge and use within 3–4 weeks for best results
Machine-Poured Precision You Can Trust
Starting April 2023, all plates are machine-poured in our state-of-the-art clean room. Using advanced MediaPrep and MediaFill systems, each batch is:
- Blended and sterilized at 18 PSI for 30 minutes
- Cooled and dispensed with exact 25ml pours per plate
- UV-C sterilized, capped, and laser-labeled for absolute consistency
Why Rhizomorphic Growth Matters
Mycelium appears in two common forms:
- Tomentose (cottony): Fluffy or matted growth, common in mixed-genetic plates
- Rhizomorphic (threadlike): Strong, rope-like strands—preferred by experienced growers for faster colonization and larger flushes
Rapid Rhizo plates help you select and preserve the most robust rhizomorphic growth for future transfers.
What Is Agar? How Do I Use It?
Agar is a foundational tool for mushroom cultivation. Just add a drop of spore solution to the plate and incubate. Within days, white mycelium will form—letting you isolate strong genetics while keeping contaminants at bay.
Once you’ve identified clean growth, transfer a small section into a spawn bag, jar, or liquid culture and watch your strongest genetics flourish.